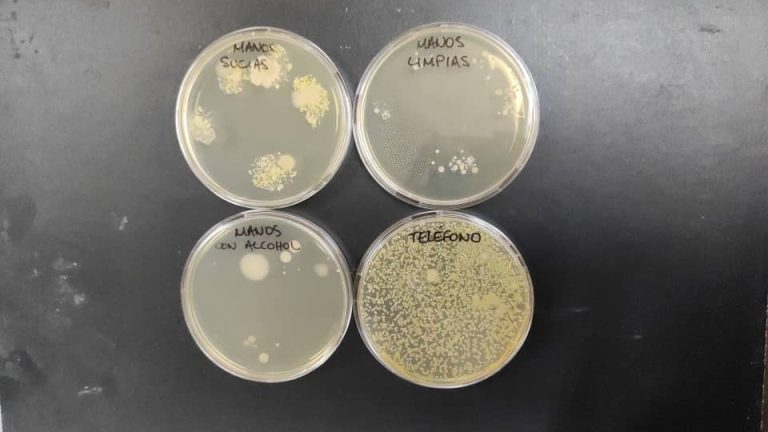

“Soy tímida y de pocas palabras, pero lo haré lo mejor que pueda”, fue su primera frase cuando le propuse una entrevista sobre su trayectoria profesional.
Isabel González Moya, de 27 años, es una de las jóvenes promesas del Laboratorio de Inmunoterapia del Cáncer, perteneciente al Centro de Ingeniería Genética y Biotecnología (CIGB).
No necesita demasiadas palabras, cuando las ideas y objetivos han sido siempre claros en su vida. La temprana vocación por la ciencia es muestra de ello.
“Mis padres son científicos. Recuerdo que un día mi mamá -graduada de Bioquímica-, nos compró a mi hermana y a mí un microscopio de batería que venía con su set de cristales, portaobjetos y pinzas, donde colocábamos todo lo que nos llamara la atención. También veíamos a nuestro papá, químico de profesión, analizando espectros en la computadora y, poco a poco, se fue manifestando la empatía por la ciencia”, rememora.
Con precisión absoluta, esta habanera recuerda el día que decidió ser microbióloga. “Fue en la primera clase de Biología de décimo grado, en la Lenin. Me pareció fascinante el mundo de los microorganismos y me enamoré de ellos”.
Luego vendrían los estudios universitarios en la Facultad de Biología de la Universidad de La Habana, donde el estrés era mucho, pero la complicidad entre todos en el aula, el compañerismo y descubrir las nuevas caras de la ciencia, hacían más llevadera la enseñanza.
Desde tercer año de la carrera, las prácticas pre-profesionales de la universidad le permitieron adentrarse en profundidad en el CIGB. La experiencia le gustó tanto que se quedó hasta hoy, en el mismo proyecto de investigación.
De las cosas que recuerda con más cariño en su primer quinquenio de trabajo profesional, menciona cuando conoció los resultados de efectividad de Abdala, o el momento en que sus dos primeras estudiantes defendieron la tesis de Licenciatura, el año pasado. “Para mí fue una prueba de fuego, pero todo el esfuerzo valió la pena al verlas exponer con tanta fluidez y seguridad el trabajo”, dice.
También ha apreciado los momentos más sencillos, como las ferias de ciencia en las escuelas y barrios. Como Isabel es microbióloga, casi siempre se encarga del experimento manos sucias-manos limpias, que consiste en explicar a los niños, a través de una placa de crecimiento de microbios, la importancia del correcto lavado de las manos.

Otra gran alegría de estos años fue la defensa de su maestría. “Los títulos se entregaron en la jornada del aniversario del centro, en mi caso fue de manos de mí mamá. Se trató de un momento muy emotivo para mí, y para ella más”.
Los padres de Isabel trabajan en distintos departamentos del CIGB y su hermana es profesora de la Facultad de Química de la Universidad de La Habana. Es una familia donde la ciencia viene de antaño, desde los abuelos paternos, que impartían clases de Química y Matemática.
¿Cómo es entonces la dinámica de una familia de científicos? ¿De qué se habla en casa?… “Hablamos de todo un poco, como cualquier otra familia, solo que, cuando conversamos de trabajo, son cosas científicas”.
En su tiempo libre, la joven microbióloga aprovecha para compartir con su pareja, ver series y leer. Ahora tiene un poco más de tiempo que hace unos años. Durante la pandemia de Covid-19, en el CIGB “no se paraba para nada”.
“Recuerdo los comentarios de mis padres cuando nos solicitaron apoyo para el análisis de muestras de pacientes de los ensayos clínicos, casi al día siguiente de diagnosticar el primer caso. Lo primero que preguntaron fue ‘y qué vas a hacer’. La siguiente expresión de mi papá fue ‘métele’”.

Isabel tiene muchos sueños por cumplir. Entre ellos, defender el doctorado y ver como producto comercializable las moléculas que investiga, sobre todo, que estas tengan un impacto favorable en la salud de los cubanos.
Le preocupa que, al igual que otras instituciones, el CIGB pierde trabajadores jóvenes. “Cuando nos graduamos, cinco compañeros de mi aula fuimos a trabajar a la institución. Ahora solo quedamos dos”.
No obstante, tiene confianza en un mejor futuro y su mensaje para los muchachos que quieren optar por carreras como la suya es que el aprendizaje nunca termina, así que deben estudiar mucho y dominar el Inglés, porque la mayoría de la literatura es en ese idioma.
Para ella, la ciencia debe ser un asidero y guiar cada proceso de desarrollo del país.